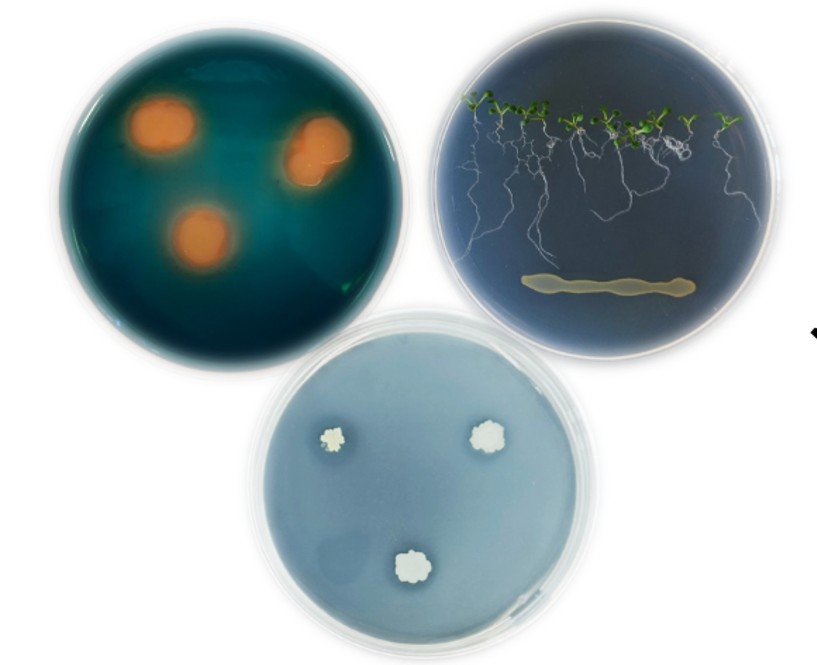

Spectatori salutem! Tisztelt Hölgyem, Uram! Kedves Kollégám!
Köszöntöm a Magyar Mikrobiológiai Társaság (MMT) honlapján. Az 1951-ben alapított MMT tagjai a mikrobiológia valamennyi jelentős ágát képviselik. Az alapítók szándékának megfelelően a Társaság célja a mikrobiológia valamennyi területének fejlesztése Magyarországon. Ennek érdekében szerteágazó tevékenységet végez. Kiemelem, hogy a Társaság minden páros évben nagygyűlést rendez (az előadások nyelve magyar). A páratlan években az International Congress of the Hungarian Society for Microbiology, ill. a Central European Forum for Microbiology nemzetközi konferenciák váltakoznak. Konferenciáinkon a résztvevők a bakteriológia, immunológia, ipari mikrobiológia, környezeti mikrobiológia és biotechnológia, mezőgazdasági és élelmiszer mikrobiológia, mikológia, parazitológia, virológia legtágabban értelmezett területén szervezett szekciókban tartanak tudományos előadásokat és mutatnak be posztereket. A konferenciák első napján egy-egy kiemelt fontosságú kérdéskört járunk körül. Társaságunk minden év április végén esedékes közgyűléséhez is előadóülés csatlakozik, amelyet a Magyar Tudományos Akadémia Mikrobiológiai Osztályközi Bizottságával együtt a mikrobiológia valamely aktuális területéről szervezünk. Meghívott nemzetközi előadóink területük kiemelten jegyzett képviselői.
A Társaság a MOTESZ (Magyar Orvostudományi Társaságok és Egyesületek Szövetsége) tagja. Ugyancsak tagja az IUMS (International Union of Microbiological Societies) és FEMS (Federation of European Microbiological Societies) nemzetközi társaságoknak. A MOTESZ a Társaság javaslatára tagokat delegál a UEMS-SMM (Union of European Medical Societies szervezetben Section for Medical Microbiology) szakmai szekcióba.
Amennyiben műveli és/vagy tanulja a mikrobiológia valamelyik ágát de még nem MMT tag, bár szeretné élvezni a tagsággal járó előnyöket, kérem vegye fel a kapcsolatot az MMT Vezetősége bármelyik tagjával, vagy keresse fel honlapunk csatlakozási felületét a Tagfelvétel gombra kattintva.
Köszöntéssel,
Kónya József
a Magyar Mikrobiológiai Társaság elnöke
TOVÁBB A MIKROBIOLÓGIA VILÁGÁBA
Tájléptékű hatások a szőlőültetvények gombaközösségeire egy élőhelymozaikban
|
A szőlőültetvények egészségét nemcsak a talaj és a termesztéstechnológia határozza meg, hanem a környező táj rejtett mikrobiológiai folyamatai is. Vajon milyen szerepet játszanak az őshonos cserjék és gyümölcsfák a szőlő mikrobiomjának alakításában? Kutatásunk az egri borvidék dűlőiben vizsgálta, hogyan formálják az eltérő abiotikus és biotikus tényezők a gombaközösségek összetételét. Eredményeink rávilágítanak arra, hogy a féltermészetes és mezőgazdasági rendszerek szoros kapcsolatban állnak egymással, és a tájléptékű hatások kulcsszerepet játszhatnak a fenntartható szőlőtermesztésben és a növényvédelem új megközelítéseiben. |
![]() |
Gomba-baktérium interakció: barát vagy ellenség?
| Az invazív Candida fertőzések gyakran társulnak polimikrobiális, ezen belül is bakterium–gomba asszociált fertőzésekhez, amelyek hátterében a különböző mikroorganizmusok közötti kommunikáció kiemelt szerepet játszik. A bemutatott vizsgálat célja az volt, hogy feltárja a Pseudomonas aeruginosa által termelt quorum sensing molekula, az N-(3-oxododekanoyl)-L-homoszerin-lakton (HSL) hatását a klinikailag jelentős Candida auris fajra, valamint összehasonlítsa azt a jól ismert Candida albicans válaszaival. | ![]() |
Saccharomyces cerevisiae, azaz pékélesztő, mint ritka opportunista patogén
|
A Saccharomyces cerevisiae hosszú ideig ártalmatlan élesztőként élt a köztudatban, ám az utóbbi években egyre több bizonyíték utal arra, hogy bizonyos körülmények között opportunista kórokozóvá válhat. Különösen figyelemre méltó a probiotikumként széles körben alkalmazott altípus, a S. ‘boulardii’ szerepe, amely bár általánosan biztonságosnak tekintett (Generally Recognized as Safe, GRAS), bizonyos esetekben invazív fertőzésekkel is összefüggésbe hozható. A faj genetikai sokfélesége és klinikai jelentősége új megvilágításba helyezi az élesztők szerepét a humán fertőzésekben, és felveti a pontos azonosítás, valamint a célzott antifungális terápia fontosságát. |
![]() |
Solanum lycopersicum-eredetű defenzin biofungicid potenciáljának vizsgálata
|
A kémiai szerekkel szemben ellenálló növénypatogén fonalasgombák által okozott termésveszteség miatt, megnőtt az igény új, környezetbarát antifungális stratégiák kidolgozására. A széles körű gombaellenes hatású, alacsony citotoxicitású növényi defenzinek ígéretes biofungicid jelöltek lehetnek, ezért kutatócsoportunk egy paradicsomnövény (Solanum lycopersicum L.) eredetű defenzint (K4CBP6) és annak szintetikus peptidszármazékát (K4CBP6γ2) vizsgálta és jellemezte. Eredményeink alapján a Komagataella phaffii-alapú expressziós rendszer alkalmas a rekombináns K4CBP6 (rK4CBP6) előállítására. Az rK4CBP6 és a K4CBP6γ2 hatékonyan gátolják növénypatogén fonalasgombák növekedését in vitro és növényvédelmi kísérletekben, miközben nem mutatnak citotoxikus hatást humán sejtvonalakon, állati és növényi modellorganizmusokon. Ezek alapján az rK4CBP6 és a K4CBP6γ2 ígéretes biofungicidek lehetnek, alacsony citotoxicitásuknak és antifungális hatásuknak köszönhetően. |
![]() |
A sit1 gén szerepe a Mucor lusitanicus csírázásában és virulenciájában
![]() |
A mucormikózis egy életveszélyes fertőzés, melyet a Mucorales rendbe tartozó gombák okoznak és incidenciája az utóbbi években növekvő tendenciát mutat. Különösen veszélyeztetettek a kezeletlen diabetes mellitus-ban szenvedő betegek, a hematológiai rendellenességben szenvedők és a deferoxamin kezelésben részesülők. A patogén gombák számára elengedhetetlen a vas, melyet több mechanizmussal képesek felvenni a gazdaszervezetből, például sziderofórok segítségével. A Mucor lusitanicus genomja egy Sit1 sziderofór transzportert kódol. Munkánk során a sit1 gént CRISPR-Cas9 módszerrel kiütöttük. A gén hiánya megváltoztatta a spórák csírázási képességét és a gomba növekedését, valamint csökkentette a virulenciáját. Emellett több vasfelvételben szerepet játszó gén (fre, fet3, fet4) kifejeződése megnőtt. Ez arra utal, hogy a vasfelvételi rendszerek egymással összefüggve szabályozódnak, és a Sit1 hiányát más mechanizmusok részben kompenzálhatják. |
Új korszak a gombaellenes terápiában: Növényi eredetű peptidekkel a rezisztencia ellen
| A súlyos, gyakran halálos kimenetelű gombafertőzések világszerte növekvő klinikai terhet jelentenek, miközben a rendelkezésre álló terápiák hatékonyságát a növekvő rezisztencia és a jelentős mellékhatások korlátozzák. Ezért előtérbe kerülnek az új, természetes eredetű hatóanyagok, melyek új támadáspontokat nyithatnak a kórokozók ellen. Kutatásaink során kémiai szintézissel előállított növényi eredetű gümőspecifikus ciszteinben gazdag peptidek (NCR) hatását vizsgáltunk, melyek nemcsak közvetlen antifungális hatást mutatnak a Cryptococcus neoformans ellen, hanem az immunválaszt is képesek fokozni. E kettős hatás révén új távlatokat nyithatnak a korszerű, célzott antifungális terápiák fejlesztésében. | ![]() |
Extremofil baktériumok magashegységi olvadéktóban az Andokban
![]() |
A Föld élőhelyeinek egyik különleges csoportját képezik azok, ahol kizárólag extrém körülményekhez alkalmazkodott mikroorganizmusok (extremofilek) képesek életben maradni. A szélsőséges feltételek igen változatosak lehetnek, és gyakran együttesen jelentkeznek a természetben. Az extremofilek kutatása közelebb visz minket többek között a Földi élet kialakulásának és a korai mikroorganizmusok adaptációjának megértéséhez. |
Antibiózis gombafajok között
| Műemlék védelem alatt álló freskómaradványokkal borított beltéri falakról izolált penészgombák azonosításáról és egy biomolekulán alapuló védekezési lehetőségről számolunk be. | ![]() |
Kozmopolita Alternaria gombák a szőlőn
|
A szőlőt kolonizáló endofiton gombák között jelentős számban fordulnak elő az Alternaria nemzetség tagjai. Az endofiton gombák életük egy szakaszában úgy élnek a gazdanövényben, hogy nem okoznak látható tüneteket.
|
![]() |
Növekedést és terméshozamot serkentő baktérium az édesburgonyán
![]() |
A hosszútávon fenntartható mezőgazdaságban kiemelt szerep jut a mikrobiológiai alapú készítményeknek (pl. talajoltó készítmények, lombtrágyák), amelyek alapját sok esetben úgynevezett növényi növekedést serkentő baktériumok képezik. |
Vírusvadászat, avagy hogyan kutatható egy vírus, ha nincs is vírus
A vírusok utáni célzott vagy random „vadászat” sikerességét jelentősen megnövelte a szekvenálási technikák fejlődése. Lehetővé vált, hogy ismert kórképek addig ismeretlen kórokozóit azonosítsuk; hogy egy új fertőzés, járvány esetén gyorsan megtaláljuk a kórokozót, ahogy ez a SARS-CoV-2 esetében is történt. Ugyanakkor sokszor puszta „genomvadászat” zajlott/zajlik, vagyis nem klinikai tünetek miatt, hanem teljesen random mintákból új szekvenciákat keresnek és írnak le. Mindezeknek köszönhetően jelentősen megnőtt az új, korábban nem ismert vírusok száma. A felfedezéskor a vírusok nagy többségét nem izolálták, nem tudunk betegséget társítani hozzájuk, gyakorlatilag szinte semmit nem tudunk róluk. Puszta genomszekvenciaként „léteznek”, nincs vírus, amellyel a laboratóriumban dolgozhatnánk. Ez új kutatási területet nyitott meg.
Baktériumok az édesvizek diklofenák gyógyszerszennyezése ellen
A diklofenák, egy széles körben alkalmazott nem-szteroid gyulladáscsökkentő gyógyszer, amely egyre nagyobb koncentrációban mutatható ki édesvízi ökoszisztémákban. Napjaink egyik legsürgetőbb környezeti problémájává váltak ezen szennyezési források. Jelen tanulmányban a Stenotrophomonas humi DIC_5 baktériumtörzs diklofenák-lebontó képességét vizsgálták. A baktérium 75,1%-os hatékonysággal képes volt biotranszformálni a diklofenákot 1,5 mg/L kezdeti koncentráció mellett, 8 nap alatt, 3,0 g/L glükóz jelenlétében.
A SARS CoV-2 atomi erő mikroszkópos vizsgálata
| A Semmelweis Egyetem Biofizikai és Sugárbiológiai Intézet és a Nemzeti Népegészségügyi Központ Nemzeti Biztonsági Laboratórium munkatársai natív SARS-CoV-2 virionok atomi erő mikroszkópos vozsgálatával kimutatták, hogy a vírusrészecskék mechanikai és hőmérséklet hatásnak meglepően ellenállók. Cikkük a Nano Letters folyóiratban jelent meg. | ![]() |